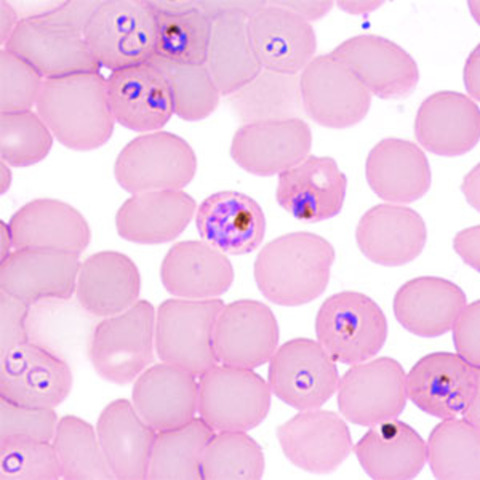
GIBH

-
Pfizer annouces closure of its Saint Louis research facilities. A number of scientist became available to the labor market over the next following months.
-
Saint Louis University announces that it will establish a new center to combat neglected and orphan diseases in an effort to help preserve scientific talent in the Saint Louis area.
-
The Center for World Health and Medicine opens its doors at the Doisy Research Center at Saint Louis University. Its initial staff includes 11 pharmaceutical scientist.
-
CWHM initiates its first in vivo studies to combat childhood diarrhea. Initial compounds tested are Racecadotril (left) and Loperamide (right).
-
First biochemical assays initiated at the CWHM. The assay looks at NEP enzyme activity using a synthetic substrate and is a key assay in the fight against Childhood Diarrhea
-
Fluorescence polarization probe for HSP90
-
First HSP90 Binding assay is executed at CWHM
-
First potential drug candidate is synthesized at CWHM
-
CWHM partners with China's Guangzhou Institutes of Biomedicine and Health to combat malaria
-
First drug sythesized in effort to combat malaria in collaboration with GIBH in China
-
First erythrocyte assay in collaboration with GIBH, testing the first compounds synthesized for this project.
-
CWHM and Institute for One World Health join forces to combat childhood diarrhea, the second leading cause of death in children under 5 in developing countries.
Plan projects on a visual timeline
Map milestones, phases, deadlines, and key events in one place so the sequence is easier to see and share. Timetoast is a timeline maker for work, school, research, and stories.